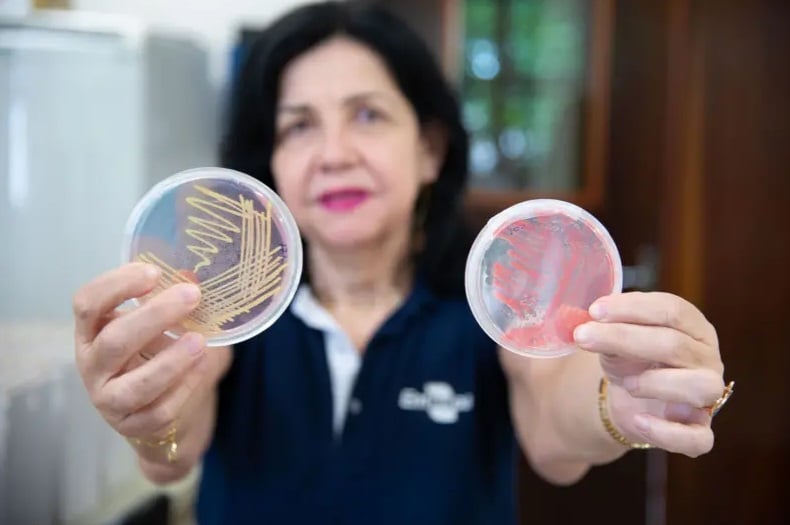
Brasileira vence Nobel da Agricultura por inovação sustentável

Você já pensou que os continentes que vemos hoje podem desaparecer, para depois se reunir como se tudo voltasse ao ponto de partida? Pois alguns modelos científicos sugerem exatamente isso: um novo supercontinente poderia surgir, e o Brasil teria “convite” especial para entrar nessa festa geológica.
Qual seria o nome desse supercontinente?
Há várias hipóteses em jogo. A mais citada é Pangeia Próxima (também chamada de Pangeia Próxima, Pangeia Última, Neopangea ou Pangea II). Trata-se de um cenário especulativo em que, daqui a 250 milhões de anos, os oceanos e placas tectônicas convergiriam novamente para formar uma grande massa de terra.
Outro nome menos dramático mas também discutido é Amasia, modelo em que América do Norte e Ásia colidem e formam um supercontinente concentrado mais ao norte.
Como o Brasil “entra” nessa história?
Em alguns desses cenários, especialmente os que envolvem fechamento do Atlântico e movimentos de subducção nas bordas oceânicas, o Brasil poderia aproximar-se da África e da Europa, juntando-se ao novo bloco de terra. A modelo de Pangeia Próxima prevê que a parte leste da América do Sul se reconecte com a África.
Há também hipóteses alternativas, como “Aurica”, que projetam fusões diferentes com base em previsões de movimento de placas, mas são menos populares.
O que a literatura científica realmente apoia?
Vale dizer: tudo isso é especulativo. Modelos geológicos que prevêem formação de supercontinentes são baseados em tendências de placas tectônicas atuais e comparações com ciclos passados.
Um estudo publicado pela Science sugere que Eurasia e Américas poderiam colidir no futuro, gerando um supercontinente, talvez algo como a ideia de “Amasia”.
Mas projetar isso para centenas de milhões de anos no futuro envolve muitas incertezas: taxas de movimento das placas podem mudar, novas zonas de subducção podem surgir, forças mantélicas podem agir de modo imprevisível.
Onde essa “festa geológica” pode acontecer
Alguns modelos mostram que o Atlântico pode começar a se fechar em suas bordas, empurrando a América do Sul para frente, enquanto a África também migra. Isso faria com que os continentes “voltassem a se abraçar”. Essa hipótese alinha-se com a ideia de Pangeia Próxima
Já o modelo de Amasia coloca a fusão mais para o lado norte, com a América do Norte colidindo com a Ásia, e pouca participação da América do Sul no centro desse novo bloco.
Limitações: ciência não é bola de cristal
Essas projeções são interessantes e inspiradoras, mas não garantidas. Muitas variáveis podem alterar o destino das placas: surgimento de novas rupturas, variações de fluxo no manto da Terra etc.
Geólogos lembram que, no passado, previsões de longo prazo já “eram” certas e depois foram revistas. Ou seja: muito cuidado com interpretá-las como destino inevitável.
Essa hipótese é fascinante
Mesmo com as incertezas, é um exercício de imaginação científica sobre o que pode acontecer com nosso planeta em escala gigantesca. Pensar em continentes se unindo de novo nos força a ver a Terra como organismo vivo, em movimento constante.
Com informações de Fatos Desconhecidos.